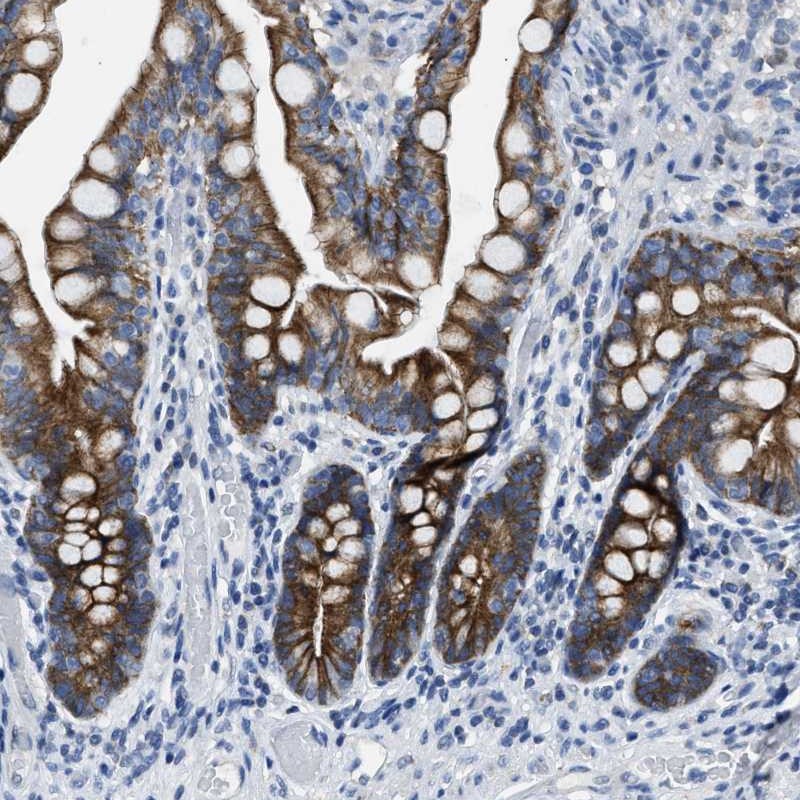
Anti-MRPL39 Antibody

All products are designed for the highest possible performance and are manufactured using a standardized process to ensure the most rigorous levels of quality.
Corresponding antigens
With Atlas Antibodies you get

From our facilities in Stockholm, Sweden we develop, manufacture and distribute highly advanced reagents to the Life Sciences community worldwide.

Our products are available to customers worldwide. From most locations, you can order our products from Atlas Antibodies. Please see more information about how to order here.

Learn how we validate our antibodies, how we secure their reproducibility, and why we apply enhanced validation. Our antibodies are validated in IHC, ICC-IF, and WB.

![Lane 1: Marker [kDa] 230, 130, 95, 72, 56, 36, 28, 17, 11_br/_Lane 2: Human cell line RT-4_br/_Lane 3: Human cell line U-251MG sp](/thumb/29552/142x0/HPA018331-wb-3.webp)

